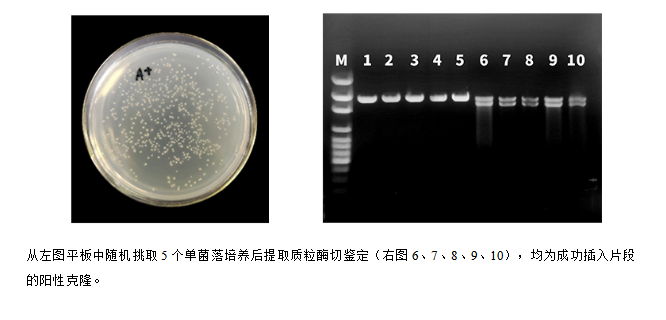

· 兼容—可一次实现单至多个DNA片段的重组,能一定程度上耐受未纯化的PCR产物中含有的杂质
· 高效—单片段重组最快仅需5分钟
· 可靠—采用的Gibson Cloning原理经多篇论文验证">
序号 规格 价格 促销活动 促销价 购买
E001020 20次制备 ¥500 特惠福利 ¥300 拨打客服电话
E001050 50次制备 ¥1000 特惠福利 ¥600 拨打客服电话
产品介绍
本产品是基于重组原理开发的无缝克隆试剂盒,该试剂盒能实现简单、快速、高效的DNA定向克隆。
作为新一代的克隆方法,不受酶切位点的限制,通过DNA片段与线性化载体末端的15~25 nt同源序列的重组,从而将插入片段重组至线性载体的任意位置,且载体自连背景极低。本产品可一次实现单至多个DNA片段的重组,单片段重组最快仅需5分钟。
本产品中添加的辅助因子,能有效提高克隆阳性率;优化后的反应体系能一定程度上耐受未纯化的PCR产物中含有的杂质,因而具有更高的阳性率和更好的兼容性。
产品储存与有效期
-20℃以下保存有效期为两年以上;如果经常使用,为避免反复冻融,请于2~8℃保存,有效期为6个月。
实验数据

M:DL5000 DNA Ladder
pUC19上面条带为二聚体,下面条带为超螺旋结构
1~10:在pUC19加上500 bp片段经同源重组、转化后,挑单菌培养提取的质粒。
由上图可以看出,提取的重组质粒的长度均长于pUC19超螺旋质粒,证明挑取的10个单菌落均为阳性菌落。